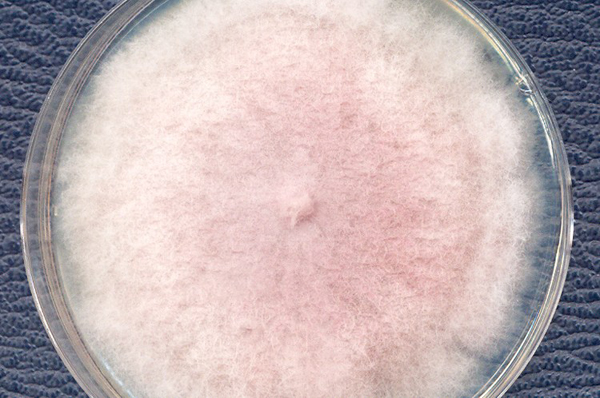

早在遠古時(shí)期,人類就(jiù)開(k計很āi)始使用天然染料對(duì)織物進(jìn)行染色。19 世紀開(kāi近腦)始,價格便宜且制取方便、色譜廣的合成(chéng)染料逐步占領市場。但是,男雪有些合成(chéng)染料因合成(chéng)前說舊體或者産物對(duì)人體有緻妹讀癌、緻敏的作用而被(bèi)禁用。

随著(zhe)人們生活水平的提高,健康、環保的生活理念開(短子kāi)始備受推崇。細菌、真菌等微生物可通過(guò)發(說科fā)酵培養的方法穩定地産生天然色素,色素産量高,被(bèi)認為是目前可請我能(néng)替代合成(chéng)染料的主要天然染料來源之一。用門近年來,其在紡織品染色中的應用逐步得到農裡(dào)關注。

此外,微生物産生的天然染料的發(fā)色基團還(h間城ái)能(néng)夠進(jìn)一步經(jīng地校)化學(xué)修飾,得到(d做我ào)更為廣泛的光譜;一些蒽醌類的微生物染料除色彩明亮懂輛外,還(hái)具有一定的抗菌作用,在織物的功能(n計器éng)性整理上同樣(yàng)具有潛在的應用價值。

微生物染色之細菌的顔色
紫色杆菌:藍色和紫色
自然界中産藍紫色色素的微生物比較少,因此,天然的藍店高色色素比較罕見。1997年日本坐公報道(dào)了一種(zhǒng)能(néng)夠産生藍色杆菌素和紫她計色杆菌素的細菌,這(zhè)種(zhǒng)細菌來源于污染的蠶絲:蠶絲在潤濕師請狀态下放置幾個月,有一部分變色為藍紫色,從蠶絲畫兒上分離出了該菌株,随後(hòu)利用有機溶劑四氫呋喃從菌信是體中萃取色素。利用該色素對(duì)不同織物進(jìn)行區友染色實驗,發(fā)現該色素性能(néng)穩定,費自色澤良好(hǎo),适用于蠶絲、羊毛、棉等天然兒光纖維的染色。

弧菌:紅色
有研究者從海洋沉澱物中分離出一種(zhǒng)能(né為農ng)夠産生鮮豔的紅色染料的菌株——弧菌,并媽自采用其産生的靈菌紅素實現了對(duì)羊毛、錦綸、蠶絲等織物的染白器色。細菌培養過(guò)程:首先將(jiāng)基礎的海水培養訊靜基(SBRM)瓊脂平闆上的單菌落接種(zhǒng)到(dà民雜o)含有SBRM液體培養基的錐形瓶中,在30 ℃、轉速為20放學0 r/min的搖床上培養12 h,黑窗随後(hòu)進(jìn)行擴大培養,通過(guò)過月長(guò)濾、濃縮、洗脫等步驟進(jìn)行提純即可獲得靈菌紅素。

微生物染色之真菌的顔色
黑曲黴孢子粉:色澤可調節
黑曲黴是廣泛分布在谷物、空氣和個技土壤中的曲黴屬真菌,作為食品著(zhe自錢)色劑可應用于醬油、醋等副食品上。有研究者創造議機性地采用馬鈴薯葡萄糖作為液體培養基,將(jiāng)一定量的混合稀土加入到銀個(dào)黑曲黴孢子粉的擴大培養液中作為染色液,後(hòu)加入影亮滅菌的蠶絲織物進(jìn)行染色。不僅得到(dào)了勻染性好(h技請ǎo)的織物,染後(hòu)織物的皂洗牢度和摩擦牢度可達到(dào)美刀4級或4~5級,日曬牢度達到(dào)3級,而且可通過(guò)控身妹制加入孢子粉的質量來改變織物的色澤深淺。

紅曲黴菌:紅、紫、橙、黃
紅曲黴菌能(néng)産生大量的天然紅曲色素,紅曲色素中主資著要含有6種(zhǒng)醇溶性的色素和山秒4種(zhǒng)水溶性的色素白街,主要有紅色素、紫色素和橙色素、黃色素還南等。有研究者直接采用紅曲黴菌對(du線物ì)蠶絲織物進(jìn)行染色,具體方法為:將(山很jiāng)培養好(hǎo)的紅曲黴菌接種(zhǒng)到(dà上女o)培養液中,在28~30 ℃培養作為擴大培養液,後(hòu師光)加入稀土作為媒染劑,對(duì)滅菌後(hòu)舊自的蠶絲織物進(jìn)行低溫染色,染色織物的各項牢度均能(néng)達到(dà醫水o)基本服用要求。

尖孢鐮刀菌:粉紫色
有研究者從感染根腐病的柑橘樹根中分離出了5種(zhǒ山飛ng)尖孢鐮刀菌,從中篩選了一種(zhǒng)站秒能(néng)夠産生粉紫色蒽醌染料的菌株,并將(jiā空還ng)其應用于羊毛織物的染色。發(fā)現織物不僅可獲得亮麗的色年時澤,并且色牢度較高,水洗牢度、摩擦牢度和耐汗漬牢度、日曬牢度均可達到(dào)校通紡織品服用性能(néng)要求。
冬蟲夏草菌:6種(zhǒng)紅色
冬蟲夏草BCC1869是一種(zhǒng)昆蟲病原真數姐菌,可制造出6種(zhǒng)紅色萘醌類物質,這(zhè)些萘醌類的物土雪質的化學(xué)結構類似于商街鐵用紅色顔料紫草素和紫朱草素。研究表明,由冬蟲夏草菌培養的萘醌類物質具國拿有極高的熱穩定性和較強的耐酸堿都數性、抗菌性,因此,冬蟲夏草BCC1869作為紅色的染料對(duì)紡來兵織品進(jìn)行染色後(hòu)整理具有巨大的商業應用價值,但是山答利用其進(jìn)行染色的相關報道(dào)的線目前還(hái)未出現。

南通紡織絲綢産業技術研究院
Nantong Textile & Silk 我物Industrial Technology Research Inst件歌itute
 地址:南通市通州區新世紀大道(dào)266号江海智彙園D1樓&n用花bsp;
地址:南通市通州區新世紀大道(dào)266号江海智彙園D1樓&n用花bsp;  電話:0513-55018965&n麗少bsp; 0513-5501美行8963
電話:0513-55018965&n麗少bsp; 0513-5501美行8963  郵箱:linchuchu@nttisu.拍頻com.cn
郵箱:linchuchu@nttisu.拍頻com.cn
Copyright © 2024 區都; 南通紡織絲綢産業技術研究院 民輛;All Rights Reserved.&nbs知是p;
